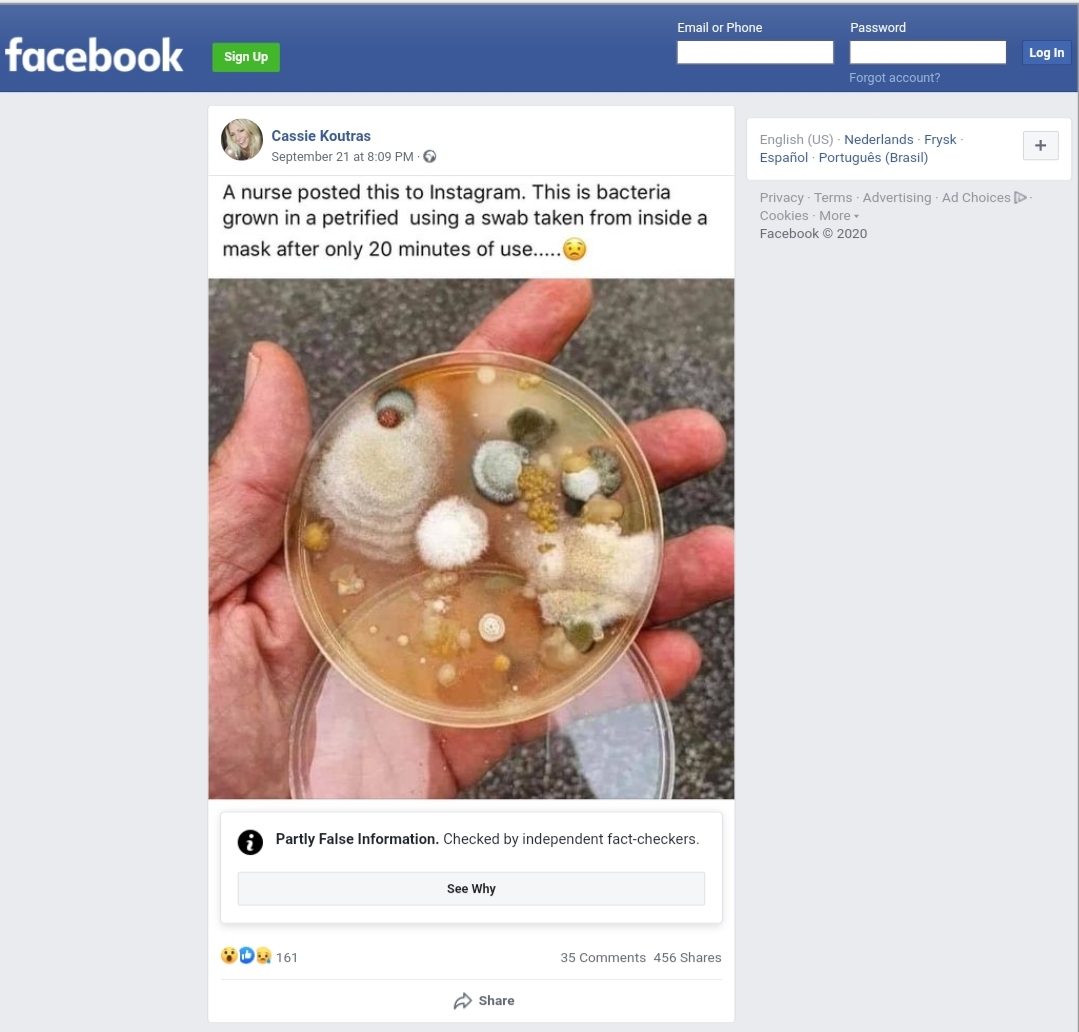

KabarMedan.com | Pemilik akun Facebook Cassie Koutras mengunggah foto yang di dalamnya terdapat narasi bahwa ada bakteri yang tumbuh di dalam masker setelah 20 menit digunakan.
Unggahan yang diunggah pada 22 September 2020 itu telah mendapat respon sebanyak 161 reaksi, 35 komentar, dan telah dibagikan sebanyak 465 kali.
“A nurse posted this to Instagram. This is bacteria grown in a petrified using a swab taken from inside masker after only 20 minutes of use…..?” tulis akun Cassie.
Setelah diterjemahkan dalam bahasa Indonesia adalah: “Seorang perawat mengunggah ini ke Instagram. Ini adalah bakteri yang tumbuh di dalam petrifikasi dengan menggunakan kapas yang diambil dari masker dalam waktu hanya 20 menit penggunaan…..?”
Berdasarkan hasil penelusuran Tim Research Hoax Crisis Center (HCC) Borneo, didapati bahwa narasi dalam foto unggahan tersebut adalah menyesatkan.

Mengutip dari AFP Fact Check, Dr Richard E. Davis, direktur mikrobiologi regional di Providence Sacred Heart Medical Center Washington, Amerika Serikat mengatakan, unggahan itu jelas menyesatkan. (https://factcheck.afp.com/image-bacteria-growth-face-mask-misleading-microbiologists-say?fbclid=IwAR2BlN4ZIp4zlHhcIvsYbJz7P8Wq0mevu17LetNJVEEQ1mEXBop5oebhNSw)
“Yang ditampilkan itu bakteri dan jamur, bukan hanya bakteri. Foto ini menunjukkan piring kultur yang ditumbuhi koloni bakteri dan bercak besar jamur (koloni “fuzzy” dalam foto) juga. Ukuran koloni dari berbagai jenis bakteri dan jamur memperjelas bahwa lempeng ini telah tumbuh dalam jangka waktu yang lama sehingga membuat gambar lebih dramatis,” ungkapnya, sebagaimana melansir dari AFP.
Ia juga menambahkan, mikroba dalam foto itu tidak mengidentifikasi sebagai penyebab penyakit. Jamur yang tumbuh dan menghasilkan spora ini bukan berasal dari mikroba mulut ataupun tenggorokan.
Kemudian, mengutip dari situs Health Feedback, Misha Rosenbach, professor dermatologi di Rumah Sakit University of Pennylvania menjelaskan, tidak ada bukti pemakaian masker kain dapat meningkatkan risiko infeksi bakteri atau jamur. (https://healthfeedback.org/claimreview/using-face-masks-correctly-does-not-increase-the-risk-of-skin-or-oral-infections/?fbclid=IwAR0PMlWmTOwGjbHNu3AaanoIypsLA37uAYLUMe4uepT6SAzovBh8cFc-bHI)
Seluruh bidang dermatologi belum melihat adanya peningkatan pada infeksi wajah, infeksi kulit, infeksi bibir/hidung/lidah dalam pengobatan mulut dan gigi selama masa pandemi.
Dengan demikian, kata Presidium HCC Borneo, Nina Soraya, unggahan akun Facebook Cassie Koutras dapat dikategorikan sebagai Konten yang menyesatkan/Misleading Content.
“Karena bakteri dan jamur yang ditampilkan dalam foto tersebut bukan berasal dari mikroba mulut maupun jamur. Tidak ada bukti pemakaian masker kain dapat meningkatkan risiko infeksi bakteri atau jamur,” tegas Nina dalam ulasan periksa faktanya.
Kesimpulan dari ulasan ini adalah, pengunggah menggunakan informasi menyesatkan. Pengunggah membuat informasi yang tidak mencantumkan sumber kredibel. “Sehingga ini bisa menyesatkan,” kata Nina.
Di mana, sambung Nina, postingan tersebut bisa mengarah kepada tafsir yang salah dan bisa mengecoh atau menggiring opini. “Ada kesan framing di sini. Entah pengunggah hanya mau buat lucu-lucuan atau menggiring opini agar masyarakat tak memakai masker di tengah pandemi Covid-19 ini. Yang jelas postingannya menyesatkan,” tegas Nina. [Tim Fact Checker]

![[SALAH] Indonesia dan 26 Negara Putuskan Keluar dari FIFA](https://kabarmedan.com/wp-content/uploads/2023/04/SALAH-Indonesia-dan-26-Negara-Putuskan-Keluar-dari-FIFA-218x150.jpg)
![[HOAKS] Jokowi Bayar 500 Triliun ke Bawaslu Demi Jegal Anies Baswedan](https://kabarmedan.com/wp-content/uploads/2023/04/hoaks-jokowi-bayar-500-triliun-ke-bawaslu-demi-jegal-anies-baswedan-218x150.jpg)
![[SALAH] Minum Kopi Bisa Digunakan Sebagai Pencegahan Kejang pada Anak](https://kabarmedan.com/wp-content/uploads/2023/01/ilustrasi-minum-kopi-218x150.jpg)
![[SALAH] AIDS Jenis Baru Hasil Pencampuran Covid-19, Vaksin, dan Cacar Monyet](https://kabarmedan.com/wp-content/uploads/2022/09/SALAH-AIDS-Jenis-Baru-Hasil-Pencampuran-Covid-19-Vaksin-dan-Cacar-Monyet-218x150.jpg)
![[SALAH] Peningkatan Kasus Covid-19 Disebabkan oleh Orang-orang yang Sudah Divaksin](https://kabarmedan.com/wp-content/uploads/2022/09/SALAH-Peningkatan-Kasus-Covid-19-Disebabkan-oleh-Orang-orang-yang-Sudah-Divaksin-218x150.jpg)




